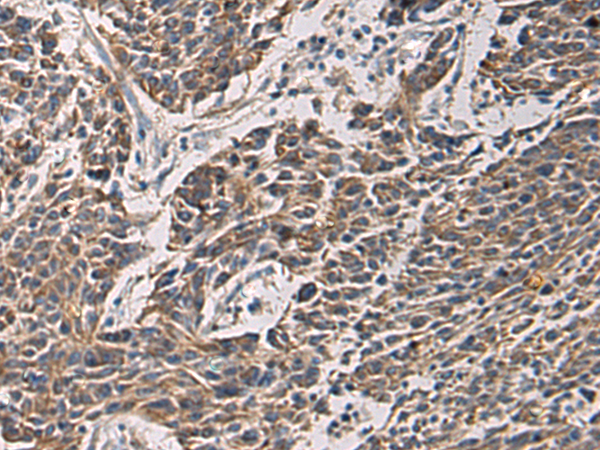

英文名稱: Anti-MAPKAPK3 rabbit polyclonal antibody
別 名: mitogen-activated protein kinase-activated protein kinase 3; 3PK; MK-3; MDPT3; MAPKAP3; MAPKAP-K3; MAPKAPK-3
相關(guān)類別: 一抗
儲(chǔ) 存: 冷凍(-20℃)
宿 主: Rabbit
抗 原: MAPKAPK3
反應(yīng)種屬: Human, Mouse, Rat
標(biāo) 記 物: Unconjugate
克隆類型: rabbit polyclonal
技術(shù)規(guī)格
|
Background: |
This gene encodes a member of the Ser/Thr protein kinase family. This kinase functions as a mitogen-activated protein kinase (MAP kinase)- activated protein kinase. MAP kinases are also known as extracellular signal-regulated kinases (ERKs), act as an integration point for multiple biochemical signals. This kinase was shown to be activated by growth inducers and stress stimulation of cells. In vitro studies demonstrated that ERK, p38 MAP kinase and Jun N-terminal kinase were all able to phosphorylate and activate this kinase, which suggested the role of this kinase as an integrative element of signaling in both mitogen and stress responses. This kinase was reported to interact with, phosphorylate and repress the activity of E47, which is a basic helix-loop-helix transcription factor known to be involved in the regulation of tissue-specific gene expression and cell differentiation. Alternate splicing results in multiple transcript variants that encode the same protein. |
|
Applications: |
ELISA, WB, IHC |
|
Name of antibody: |
MAPKAPK3 |
|
Immunogen: |
Fusion protein of human MAPKAPK3 |
|
Full name: |
mitogen-activated protein kinase-activated protein kinase 3 |
|
Synonyms: |
3PK; MK-3; MDPT3; MAPKAP3; MAPKAP-K3; MAPKAPK-3 |
|
SwissProt: |
Q16644 |
|
ELISA Recommended dilution: |
5000-10000 |
|
IHC positive control: |
Human colorectal cancer and Human brain |
|
IHC Recommend dilution: |
100-300 |
|
WB Predicted band size: |
43 kDa |
|
WB Positive control: |
HT-29 and HepG2 cell lysates |
|
WB Recommended dilution: |
500-2000 |

購物車
幫助
021-54845833/15800441009
